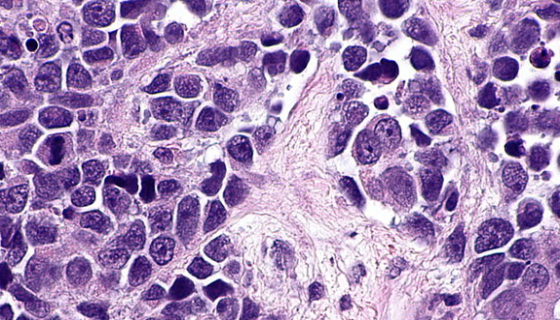
RT-112人膀胱癌细胞的处理方法与培养步骤！
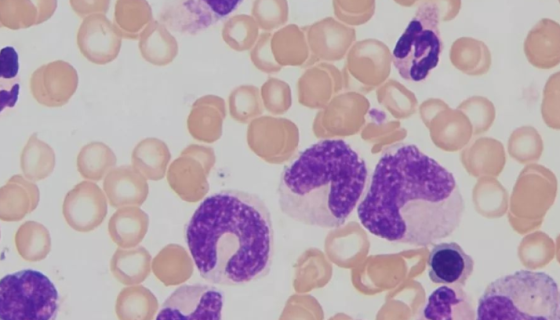
THP-1细胞的常规培养步骤及应用！
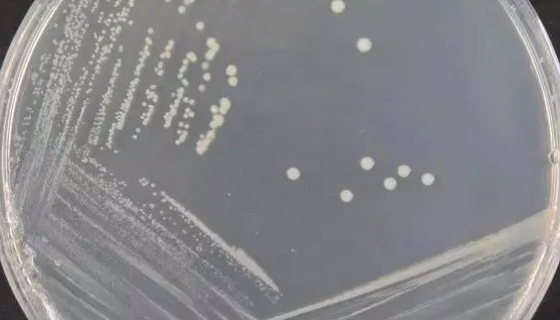
恶臭假单胞菌（带绿色荧光）的活化表达方法！
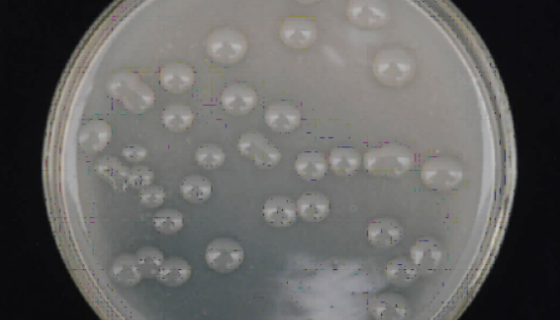
ATCC 35410 耐盐魏斯氏菌 百欧博伟生物

大鼠外周血中性粒细胞的性质与用途及生产工艺!
大鼠外周血中性粒细胞采用密度梯度离心法制备而来,细胞纯度可达...

ATCC 700970 微小脲原体 百欧博伟生物
ATCC 700970 微小脲原体的保存与培养。

小鼠鳞状细胞癌细胞收到后的处理方法与培养步骤!
小鼠鳞状细胞癌细胞的处理方法与培养步骤及注意事项有哪些?

短刺小克银汉霉的培养条件与保存方法及打管说明!
短刺小克银汉霉,属霜霉目,白锈科,菌落呈棉絮状,初白色,后略...
RT-112人膀胱癌细胞的处理方法与培养步骤!
人膀胱癌细胞仅用于科学研究或者工业应用等非医疗目的不可用于人...

ATCC 27768 普拉梭菌;普氏粪杆菌
ATCC 27768 普拉梭菌;普氏粪杆菌知识解析!
THP-1细胞的常规培养步骤及应用!
THP-1细胞是1980年Tsuchiya等人建立的人单核细...
恶臭假单胞菌(带绿色荧光)的活化表达方法!
恶臭假单胞菌,革兰阴性杆菌,有些菌株为卵圆形,单端丛毛菌,运...
ATCC 35410 耐盐魏斯氏菌 百欧博伟生物
耐盐魏斯氏菌是Weissella属的微生物,原产地为中国。主...